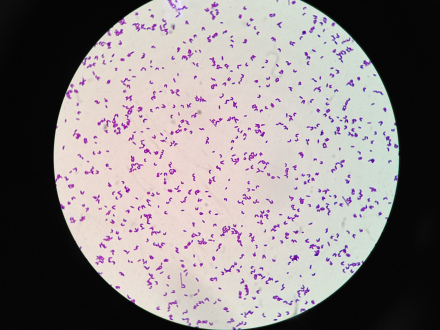

-
谷氨酸棒状杆菌 编辑
谷氨酸棒状杆菌(Corynebacterium glutamicum)是近四十年来全球用以氨基酸发酵工业的主要生产菌,早在1957年由Kinoshita首次描述其为谷氨酸产生菌。谷氨酸棒状杆菌在分类上属于革兰氏阳性真细菌下的放线纲棒状杆菌属。镜下观察细菌短杆,小棒状,两端钝圆,菌体被染成蓝紫色,为革兰氏阳性菌。谷氨酸棒状杆菌严格好氧,不运动,不产生孢子,生物素营养缺陷型。细胞壁含有meso-二氨基庚二酸、树胶醛糖、阿拉伯糖、半乳糖和短链的C22-C36分枝菌酸。
谷氨酸棒状杆菌
(1)谷氨酸棒杆菌明胶液化实验凝块稳定,为阴性。
(2)谷氨酸棒杆菌油脂水解实验培养基上未出现红色斑点,为阴性。
(3)谷氨酸棒杆菌甲基红试验呈红色,为阳性。
(4)谷氨酸棒杆菌V-P反应实验无色,为阴性。
二分裂法繁殖,由于突然折断分裂,可导致细胞排成V形、Y形或栅状,为好氧性菌。
Corynebacterium glutamicum
谷氨酸棒状杆菌是工业上主要的谷氨酸生产菌之一。该菌能够以葡萄糖、果糖、蔗糖以及一些有机酸如乙酸、乳酸、琥珀酸等为单一碳源生产谷氨酸。谷氨酸棒杆菌还是苏氨酸 、赖氨酸 的主要产生菌。
谷氨酸棒状杆菌在发酵过程中要不断地通入无菌空气,并通过搅拌使空气形成细小的气泡,迅速溶解在培养液中(溶氧);在温度为摄氏30-37℃,pH为7到8的情况下,经28-32小时,培养液中会生成大量的谷氨酸。在谷氨酸生产中,培养基中碳氮比为4:1时,菌体大量繁殖而产生的谷氨酸少;当碳氮比为3:1时,菌体繁殖受抑制,但谷氨酸的合成量大增。在发酵过程中,当pH呈酸性时,谷氨酸棒状杆菌就会生成乙酰谷氨酰胺;当溶氧不足时,生成的代谢产物就会是乳酸或琥珀酸。
1、本站所有文本、信息、视频文件等,仅代表本站观点或作者本人观点,请网友谨慎参考使用。
2、本站信息均为作者提供和网友推荐收集整理而来,仅供学习和研究使用。
3、对任何由于使用本站内容而引起的诉讼、纠纷,本站不承担任何责任。
4、如有侵犯你版权的,请来信(邮箱:baike52199@gmail.com)指出,核实后,本站将立即删除。

















